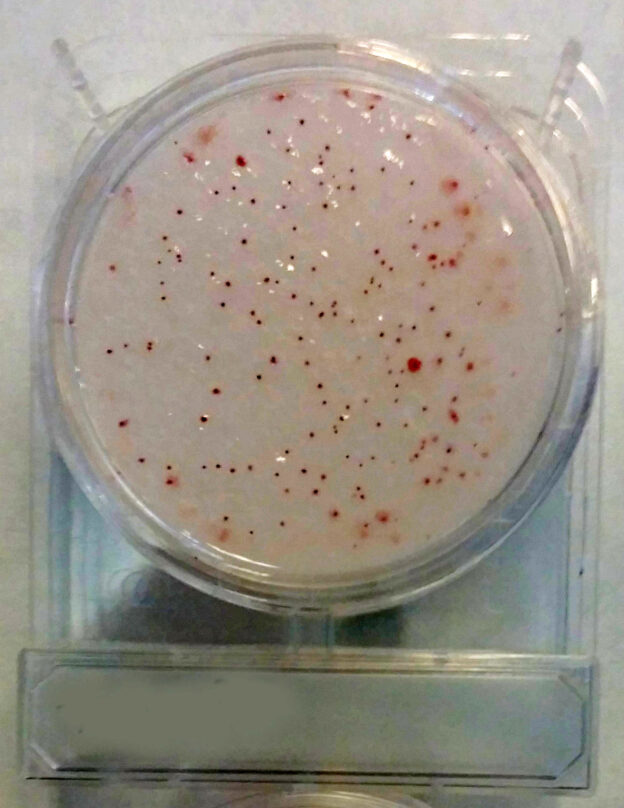

Medios de cultivo cromogénicos:
Medios cromogénicos: Motivos, ventajas, comienzos y situación actual. Del MugPlus CCA al CUP12A o al BPX19A, 2 décadas de evolución a «mucho mejor»
LAS MONOGRAFÍAS DE MICROKIT. Tema 17
MONOGRAFÍA Medios cromogénicos
1-¿Qué es un medio cromogénico, para qué sirve, qué ventajas tiene? Definición. Ventajas sobre los medios clásicos bioquímicos
Es un medio clásico al que se han añadido cromógenos que reaccionan de forma muy específica con enzimas concretas del microorganismo diana.
De modo que en vez de ser un medio bioquímico (asimilación o fermentación de fuente de carbono o nitrógeno, con indicador de cambio de pH), se convierte en un medio enzimático, mucho más específico.
Esto ahorra enormes cantidades de tiempo y de dinero en galerías y antisueros de identificación, ya que en término medio, el medio bioquímico obtiene un 30% de colonias falsamente positivas (se desperdician 30 de cada 100 confirmaciones que acaban no siendo el microorganismo buscado)…
…mientras el medio enzimático cromogénico sólo obtiene un 0,5% de colonias que hay que confirmar y luego no resultan ser la diana (se desperdician 0,5 de cada 100 confirmaciones).
Por eso el medio cromogénico no es más caro que el clásico aunque el precio por bote lo parezca (a no ser que en nuestras muestras obtengamos muy pocas colonias sospechosas).
Otra ventaja adicional es que sólo la colonia se colorea, no el medio, lo que evita lo que sucede a menudo en el medio clásico:
que unas colonias enmascaran a otras, provocando falsos negativos.
Un ejemplo típico es el Cromosalm Agar, donde entre una maraña de colonias negras de Enterobacterias acompañantes, aparecen colonias verdes de Salmonella incluso encima de las negras.
En definitiva, el medio cromogénico aumenta de forma impresionante la sensibilidad y la especificidad, es decir la eficacia (e incluso la eficiencia,
si sus muestras tienen muchos falsos positivos del microorganismo buscado y por tanto le sale más económico el medio cromogénico que el bioquímico + los kits de identificación necesarios por bote).
2-Historia del medio cromogénico. Detalles de su invención que seguramente desconoce.
En los años 80 del siglo pasado se dió a conocer el primer medio fluorogénico, gracias al MUG;
este fluorógeno se añadió a los medios para E.coli para distinguir sus colonias (glucuronidasa positivas y por tanto, fluorescentes) de las de otros coliformes, en el mismo medio.
Se empezó con dos caldos (BGBL y Lauryl) y con dos agares (VRBL, MacConkey).
Esta idea inspiró otros reactivos fluorogénicos de confirmación
-MUCAP en Salmonella y
-MUP en TSC, que hoy día se está poniendo de moda al detectar la misma fosfatasa ácida que pide (con reactivos cancerígenos) la Norma ISO 14189.
Y más adelante, se vió la necesidad de cambiar esa fluorescencia (a menudo muy subjetiva) a un cambio de color, más evidente y de visión natural e inmediata.
Los substratos cromogénicos se empleaban a principios de los años 90 como marcadores en fisiología vegetal y en Microkit se nos ocurrió desde 1990 probar qué sucedía al añadirlos a medios clásicos,
y con la ayuda de un catedrático de la Universidad de Barcelona, creamos en 1995 el primer medio cromogénico de la historia, en forma de tubo preparado: el Rapidtest,
caldo para detección rápida de aerobios.
Acto seguido, ese mismo año, creamos el primer Agar cromogénico, que encima tenía dos cromógenos (Salmon Gal para coliformes y XGlu para E.coli)…
…que llamamos MugPlus Agar en honor al inspirador MUG, mientras Merck diseñaba su propio Cromocult Coliform Agar con los mismos cromógenos o Biomerieux su Coli ID con otros similares;
los 2 primeros de estos tres pasaron a Norma ISO 9308-1:2014 con el nombre de CCA, aunque 19 años después y con un enorme gasto económico y de recursos en validaciones.
Poco después Rambach creó su famoso medio cromogénico para Salmonella con Magenta-Gal, que ha sido muy imitado pero sólo ha sido mejorado por nuestro Cromosalm Agar (denominado ABC en la actual Norma ISO 6579),
gracias al cambio de cromógeno por X-alfa-Gal, mucho más específico frente a todas las cepas de Salmonella.
Y Merck sacó un medio cromofluorogénico en caldo para E.coli (MUG) y demás coliformes (X-Gal) de gran éxito por ahorrar la campana durham, medio que derivó en su famoso Readycult (para P/A y para NMP) y en nuestro Colicult y en el tambien famoso EC Blue.
Desde entonces, ya todos los fabricantes de medios entraron en la vorágine de crear más y más nuevos medios cromogénicos para diferentes usos.
Al principio la mayoría de fabricantes no sabían termoestabilizar lo suficiente los medios con cromógenos, de modo que sólo ofrecían placas preparadas,
o a lo sumo medios deshidratados base, con el cromógeno en suplemento aparte, para que el usuario lo añadiera a 45ºC, tras autoclavar la base.
Incluso algunos vendían aún los medios con el fluorógeno MUG, con la etiqueta de “mantener a 2-8ºC”.
Más adelante, el agar-agar con termoestabilizante se dió a conocer a todos los fabricantes con el nombre de “agar-agar cromogénico”,
marcas que actualmente ya ofrecen su gama tanto de preparados como de deshidratados relativamente termoestabilizados.
3-Tipos de medios cromogénicos
Como los auténticos pioneros en la invención de medios cromogénicos, en MICROKIT ofrecemos la gama más completa del mundo,
tanto en microorganismos diana (ver capítulo siguiente), como en formatos sin límites:
-Medio deshidratado con los cromógenos termoestabilizados, incluidos en el polvo, a partir del medio deshidratado clásico.
-Medios deshidratados estériles en caldo listo para usar (Viales de polvo estéril P/A ó NMP)
– Medio deshidratado estéril en agar listo para usar en placas deshidratadas (DryPlates, que absorben 1 ml de muestra en masa a temperatura ambiente)
-Y Medio preparado estéril (placas, tubos, frascos…)
También desde el punto de vista de la solidez final del medio:
-Agares cromogénicos
-Caldos cromogénicos
Y también desde el punto de vista del objetivo del medio:
-Medios para aislamiento de patógenos
-Medios para recuentos de indicadores (aerobios, levaduras y mohos)
Hasta el punto de que podemos afirmar que los microorganismos que no tienen ya asociado un medio cromogénico, será difícil que lo tengan,
porque todas las pruebas realizadas hasta ahora han fallado (ej: Legionella spp) o porque los cromógenos adecuados son excesivamente caros (ej: Lactobacillus spp)
4-Parámetros que ya tienen medios cromogénicos asociados
–Aerobios totales
(en aguas YEA –PCA water- cromogénico y R2A cromogénico, en alimentos PCA cromogénico-MAXIM Agar, en lácteos PCA-Milk cromogénico, así como en caldo Rapidtest).
Seguimos siendo la única marca que ofrece estos medios en formato deshidratado termoestable y en medios preparados;
otras marcas sólo lo ofrecen en laminocultivos y en placas deshidratadas (nosotros también).
Colonias rojas de aerobios sobre medio color blanco-crema, muy evidentes, se distinguen de artefactos (burbujas, partículas de muestra…)
y con mayor exactitud (se ven también las colonias más pequeñas) y rapidez (el contraste permite ver mucho antes las colonias, recuentos incluso en 24h).
–Levaduras y Mohos
(Sabouraud Dextrose Agar Caf cromogénico).
Tambien somos la única marca que lo ofrece en formato deshidratado termoestable, mientras otros proveedores sólo lo ofrecen en placas deshidratadas.
Colonias verdes de levaduras y mohos sobre medio color crema-ámbar, muy evidentes, se distinguen de artefactos (burbujas, partículas de muestra…)
y con mayor exactitud (se ven también las colonias más pequeñas) y rapidez (el contraste permite ver mucho antes las colonias).
También lo ofrecemos en viales de caldo P/A estéril.
–E.coli y demás Enterobacterias.
Lo ofrecemos tanto en deshidratado como en placas deshidratadas.
E.coli crece con colonias azules, las demás enterobacterias con colonias rosas-púrpuras, sobre medio color crema.
–E.coli y resto de Coliformes.
El famoso Agar MugPlus que ahora llaman oficialmente CCA, lo ofrecemos en todas las versiones (deshidratado, preparado y en placas deshidratadas).
E.coli crece con colonias azules (desde turquesa hasta añil índigo-violeta, según la cepa),
y los demás coliformes con colonias rojizas (desde rosas hasta púrpuras, pasando por el lila-lavanda, según la cepa), sobre medio color crema.
Otras colonias (crema, amarillo…) no son coliformes y por tanto no se cuentan.
Las de color verde deben identificarse, ya que a menudo se trata de Shigella spp.
La versión ISO es menos selectiva, mientras la versión BOE incluye Cefsulodina y Vancomicina que lo hacen muy selectivo.
Y el caldo Lauryl fluoro-cromogénico que llamamos Colicult-MCC Broth y otros proveedores llaman LMX, Readycult o ECBlue, que también ofrecemos en todas las versiones (deshidratado, preparado, en frascos P/A y en viales o botes de polvo estéril).
Los coliformes viran a azul; E.coli, además, genera fluorescencia bajo luz UVA de 366 nm y, directamente, anillo de indol positivo al añadir reactivo de Kovacs.
Tambien ofrecemos desde 2021 los viales de sustrato definido ONPG en dos versiones, la ISO (con fluorógeno MUG: coliformes agua amarilla, E.coli agua fluorescente)
y la propia cromogénica (que hemos llamado ONPG+MugChrom: coliformes agua amarilla, E.coli agua verde).
Para E.coli sólo, existe el Agar TBX, un TBA con cromógeno XGlu.
Lo ofrecemos en deshidratado, en preparado y en placas deshidratadas.
E.coli crece con colonias verde-azuladas sobre medio color crema.
Pero funciona mejor el MugPlus (CCA) al no llevar Bilis inhibitoria.
–Bacillus cereus.
Nuestro XBC Agar, que ofrecemos en casi todas las versiones (deshidratado y preparado).
B.cereus crece en sólo 18 horas con sus típicas colonias de aspecto de gota de cera, pero con centro azul;
vira alrededor de sus colonias al medio base (Mossel PREP) de color salmón a rosa (sólo algunas cepas).
Otros proveedores tienen un medio similar donde en vez de azul, el centro de la colonia queda amarillo.
–Burkholderia cepacia.
Nuestro BCPT cromogénico, base piruvato, que ofrecemos en todas las versiones (deshidratado, preparado y en placas deshidratadas;
su caldo también en frascos P/A preparados y en viales y botes de polvo estéril).
B.cepacia crece en sólo 18 horas con colonias rojas, no fluorescentes.
De momento nadie más tiene medios cromogénicos para este microorganismo.
–Campylobacter spp.
Nuestro Cromokit-Campy Agar es deshidratado con el suplemento incluido, aunque en bote aparte.
Las colonias son rojas sobre fondo crema.
–Clostridium perfringens.
Nuestro Cromokit-C.perfringens es deshidratado con el suplemento incluido, aunque en bote aparte; o bien placa preparada.
Las colonias son naranjas sobre fondo crema y no pierden su color al salir de la atmósfera de anaerobiosis, como sí sucede con el medio clásico TSC.
–Enterococos fecales.
Nuestro Agar Cromokit-EPA es deshidratado y, en su versión líquida, en viales de polvo estéril.
Sus colonias crecen en sólo 18 h de azul oscuro, sobre medio color crema.
–Listeria monocytogenes.
El Cromocytogenes Agar, inventado por Ottaviani & Agosti y más conocido con el nombre comercial de Aloa, que ofrecemos en casi todas las versiones (deshidratado con suplementos aparte y preparado).
Las colonias de Listeria spp. crecen de color verde y si son de L.monocytogenes, además, generan un gran halo opaco alrededor de sus colonias.
–Pseudomonas aeruginosa.
El Cromokit Rapid Pseudomonas Agar, otro medio que sigue siendo exclusivo de Microkit, es un medio con base Cetrimida, con un cromógeno que acelera su detección a sólo 18h (colonias rosas-rojas sobre fondo blanco);
sólo los presuntos positivos deben confirmarse en 48h por la emisión de fluorescencia.
Ofrecemos todas las versiones (deshidratado, preparado, placas deshidratadas y, en su versión caldo, frascos P/A y viales y botes de polvo estéril).
–Salmonella spp.
Frente al Agar Rambach y todas sus imitaciones, que ofrecen colonias fucsia-magenta de Salmonella, nuestro Cromosalm Agar permite ver las colonias de Salmonella verdes sobre colonias negras o blancas de las demás Enterobacterias acompañantes,
incluidos los más típicos interferentes de los otros medios cromogénicos de Salmonella (Citrobacter y Proteus),
de modo que aquí se distinguen desde la primera siembra sin necesidad de perder el tiempo con confirmaciones de estos falsos positivos.
Ofrecemos todas las versiones (deshidratado, preparado y placas deshidratadas).
–Staphylococcus aureus.
Nuestro Baird Parker cromogénico Cromokit BPX19 Agar permite detectar y enumerar S.aureus sin la ambigüedad de los medios clásicos (B.Parker, Mannitol…)
ni la de otros medios cromogénicos con un solo cromógeno.
Y confirmar inmediatamente si las colonias son coagulasa positivas directamente desde las colonias sospechosas (con látex coagulasa).
Las colonias pequeñas, violáceas, son de St.aureus,
mientras las verdes suelen ser de otras especies de estafilococos;
las colonias grandes, turquesa, verdes o blancas, son de Bacillus.
Ofrecemos todas las versiones (deshidratado, preparado y placas deshidratadas).
–Vibrio spp.
Nuestro Cromokit Vibrio Agar permite detectar V.cholerae (colonias rojas) y V.parahaemolyticus (colonias azules) en una sola placa, al tener su medio base, la cantidad de sal necesaria para el crecimiento de ambos grupos de Vibrio (continentales y marinos).
Lo ofrecemos en medio deshidratado y en placas deshidratadas; y en su versión caldo, en frascos P/A.
-Antibiograma rápido
-También hemos mejorado el clásico antibiograma mediante el MHS Agar, un Agar Mueller-Hinton cromogénico…
…que permite la visión de los halos de inhibición alrededor de los discos de antibióticos de forma más evidente y rápida (desde 8 horas).
Lo ofrecemos en frascos preparados para fundir y en placas deshidratadas.
Existen otros 13 medios cromogénicos de menor uso, hasta completar los 31 medios cromogénicos de MICROKIT que hay a su disposición.
5-Los medios cromogénicos que ya son oficiales según Normas ISO y por tanto son aptos para laboratorios acreditados ISO 17025
-Como es lógico el primero es el MugPlus Agar (ahora llamado CCA),
por ser el primer medio cromogénico con más de un fabricante,
por ser los microorganismos más buscados en el mundo…
Ya es oficial según Norma ISO 9308-1 de aguas
-También es oficial según ISO 6579 de Salmonella, el Cromosalm Agar (allí llamado ABC Agar)
-El TBX Agar es oficial para E.coli en alimentos según ISO 16649.
-El caldo ONPG+MUG es oficial para E.coli y demás coliformes según ISO 9308-2.
-Y el Agar Ottaviani & Agosti es oficial para Listeria monocytogenes según ISO 11290
Los demás medios cromogénicos son precursores y acabarán en Normas ISO del futuro;
los laboratorios no acreditados ISO 17025 no tienen por qué esperar a que sean medios oficialmente reconocidos, para aprovechar desde ya sus enormes ventajas.
6-Cómo vemos el futuro de los medios cromogénicos
Tratándose de un método rápido, pero al consistir en la simple adición de sustratos cromogénicos específicos a los medios de cultivo clásicos…
…los medios cromogénicos están demostrando ser un método tan robusto (si no más) que el medio clásico;
a diferencia de la mayoría de otros métodos rápidos, al servir el medio cromogénico para muestras de todo tipo de matrices.
Por ello les auguramos el mejor futuro imaginable.
Prepárese para más de una sorpresa informativa cuando vea nuestro video sobre los medios Cromogénicos: https://www.youtube.com/watch?v=-JVPVWxY8ZE&t=271s
Si desea esta monografía completa en pdf, con las fotos que aqui no aparecen, solicítela en consultastecnicas@microkit.es
https://www.microkit.es/pdf/CROMOKIT-2021.pdf
https://www.microkit.es/fichas/MUGPLUS-COLIFORM-E-COLI-AGAR-CCA.pdf
https://www.microkit.es/fichas/ABC-CROMOSALM-MICROKIT-AGAR.pdf
https://www.microkit.es/fichas/LISTERIA-CROMOCYTOGENES-OTTAVIANI-AGOSTI-AGAR.pdf
https://www.microkit.es/fichas/cromokit-cup-12-agar–cosmetic-universal-pathochrom-agar-.pdf
https://www.microkit.es/fichas/CROMOKIT-C-perfringens-Agar.pdf
https://www.microkit.es/fichas/CROMOKIT-MAXIM-AGAR-CROMOGENICO.pdf
https://www.microkit.es/fichas/CROMOKIT-RAPID-CN-PSEUDOMONAS-AGAR.pdf
https://www.microkit.es/fichas/cromokit-lactobacillus-agar.pdf
https://www.microkit.es/fichas/CROMOKIT-ENTEROCOCCUS-EPA-AGAR.pdf
https://www.microkit.es/fichas/CROMOKIT-BURKHOLDERIA-Agar.pdf
https://www.microkit.es/fichas/CROMOKIT-B-CEREUS-AGAR.pdf
Haga sus consultas ern microkit@microkit.es
Haga sus pedidos de medios cromogénicos en pedidos@microkit.es